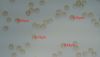

|
Recent reports
Common Scoter
Melanitta nigra - 2026-04-22 Gobi
Long-tailed Skua
Stercorarius longicaudus - 2026-04-22 Gobi
Māņsprakšķis Otho sphondyloides
Otho sphondyloides - 2026-04-22 CerambyX
Common Tern
Sterna hirundo - 2026-04-22 Gobi
Long-tailed Duck
Clangula hyemalis - 2026-04-22 Gobi
Mute Swan
Cygnus olor - 2026-04-22 Gobi
Long-tailed Duck
Clangula hyemalis - 2026-04-22 Gobi
|
Recent comments on observations
Te arī būtu svarīgi zināt, vai dzīvs koks, un vai tur bija mežs. Netradicionāls sporu izmērs. mufunja Par alksni neko nevaru teikt, nepievērsu uzmanību :( mufunja mufunja Es tā nedomāju. Tas aug uz alkšņa. Tas drīzāk izskatās pēc Badhamia. Izskatās, ka redzami arī tukši “trauciņi”. Šo vajadzētu šonedēļ mikroskopēt! Physarum cf. diderma? W W Ļoti līdzīga ir Macbrideola herreraem bet tai kājiņas apakša būtu sarkana. erihir Paldies, of course, did not check moult when I uploaded photo. Marina, šo novērojumu vajag sadalīt, vai arī pēdējos divus foto izdzēst Ja ir kājiņa, tad teiktu, ka T.decipiens kamene Ziemelmeita Paldies,Ansi, par sugu noteikšanu. Vīksna tomhi Flowers and leaves definitely G. densiflora tomhi Flowers and leaves definitely G. densiflora tomhi Flowers definitely G. densiflora tomhi Flowers and leaves definitely G. densiflora tomhi Flowers definitely G. densiflora tomhi Flowers and leaves definitely G. densiflora tomhi Flowers and leaves definitely G. densiflora Tomēr vēl būs pēcsniedzīte! :) tomhi Flowers definitely G. densiflora. tomhi Flowers definitely G. densiflora tomhi Flowers definitely G. densiflora tomhi Flowers definitely G. densiflora tomhi Flowers definitely G. densiflora tomhi Flowers and leaves definitely G. densiflora Ivetta guta7 Vīksna Vīksna zemesbite Zirņu rūsas (Uromyces pisi-sativi) bojāts augs. Mežirbe777 Kaut kas sajaukts? Domāts Pulmonaria saccharata? KM V.Grigorjevs DaceK Jā, diemžēl ir tikai šī viena bilde. Amanda Amanda Amanda 3 un 4 attēlā vidējais dzenis. Baltsvītru miežabrālis - Phalaris arundinacea fo. picta Ziemelmeita guta7 guta7 guta7 VitaS Ziemelmeita Paldies,Julita! Paraugs ir, jāmeģina atrast brīdis pie mikroskopa. Ziemelmeita Amanda Jāredz tuvāk (kaut vai izkadrēts šis pats attēls) - varbūt tumšā eļļasvabole (Meloe proscarabaeus) Ivars Leimanis Aleksejs Šarīpins 17.aprīlis, 23:37 VijaS Nē, nenobrieda līdz sporām, nesaglabāju. VijaS Bekuvecis 17.aprīlis, 15:43 InŠu 17.aprīlis, 11:47 mufunja mufunja Man kaut kā neizskatās pēc T.varia. Pēc pēdējā foto spriežot, - varētu būt paraugs? Jā, šis novērojums ļoti interesants. Žēl, ka nav skaidra plazmodija piederība. Nav pārliecības, ka te ir divi vijumi elaterai VitaP. Mežiņā pie mājām, kļavā ieurbtā caurumā (sulām). adata Siona erihir erihir Paldies, and sorry! I am struggling with latin-Latvian, species is of course leucopsis. Mežirbe777 Jāatdala, gan jau nav parastais Lietuviete Vladimirs S Ziemelmeita Paldies, Julita, par skaidrojumu. Noteikti nav Chaenotheca stemonea. Tā ir ar zaļu laponi, brūnu sporu masu. Jābūt vēl vienam simbolam, kas lasās perpendikulāri redzamajiem! Ziemelmeita Tad jau iespējams ka medainā arī apaug. Es arī īsti nezinu vai tā ir. adata Hmm, pilienīšu dzimta vien ir, par to nebiju aizdomājusies. Ko Julita teiks? adata Skaista! Šķiet, sporu masa varētu būt dzeltena. Ziemelmeita Varbūt arī Poecilus versicolor adata Teiktu, ka medainā bumbulīte. Redz vertikāli izstieptus augļķermeņus (ne pilienveida). Bet ievākts jau nav? Vērtīgs, jo ar attīstību Ziemelmeita adata Gredzenots kā pieaudzis putns 14.11.2021. Gdynia: Skwer Plymouth, POMORSKIE, POLAND. Pēc foto noteica Valdis Pilāts. Balts vēders kā klaidoņpelei, svītra pār muguru - svītrainā. Ziemelmeita adata zane_ernstreite Paldies, Julita, par apstip[rinājumu! ligausis zane_ernstreite Jā, tūlīt to arī daru, jau procesā ))) Ja novērojumu neliek caur aplikāciju, tad bildes jāpievieno pēc tam. T.i., tagad. a.b Gredzenošanas vieta: Bišumuiža, Rīga Gredzenošanas datums: 22.05.2025 a.b Amanda Vīksna It kā pēc sila strazda izskatās gints Ziemelmeita Garkāta agrenīte (Microstoma protractum). Ziemelmeita Mežirbe777 adata Te sporu mākonis ar brīviem galiem, nevis kā kamols, tāpēc nebūs vāles/apkaklītes Žēl, ka pēdas nospiedums nav nofotografēts. J. Ozoliņš atzina par lāča pēdu. J. Ozoliņš atzina par lāča pēdu. J. Ozoliņš atzina par lāča pēdu. Jānis Ozoliņš šo novērtēja kā "izcili pareizu ziņu". No šīs var mācīties, kā fotografēt lāča pēdas. adata Iveta, es nezinu :), tur jau izskatās pēc sporām. Sēnes šobrīd nepētu, nav laika. adata Nu vai tad šis nav Sorocybe resinae micēlijs, uz kura mēdz augt gļotsēne? adata megemege Bekuvecis 10.aprīlis, 11:47 kamene marsons Un, jā, mans atradums arī pie upes! Amanda zemesbite zemesbite megemege Kas par zosi? Interesanti tumšs knābis! Amanda joonc joonc V.Grigorjevs man liekas, ka tagad uz visiem laukiem tūkstošiem visādu zosu... Vīksna V.Grigorjevs Paldies par stāstu, ļoti interesanti! Jaykay5 09.aprīlis, 18:50 Ziemelmeita Ziemelmeita Paldies par labojumu! Dzeltenās sporas samaisija galvu. marsons 2025.gada pavasarī-vasarā neatradu. Skatīšos arī šogad. eera 09.aprīlis, 15:43 Katru dienu uzturas barotavā, kamēr viss no rīta noliktais apēsts . Vīksna Kārlis Levinskis 09.aprīlis, 13:44 Kārlis Levinskis 09.aprīlis, 13:44 Kārlis Levinskis 09.aprīlis, 13:44 Kārlis Levinskis 09.aprīlis, 13:43 Kārlis Levinskis 09.aprīlis, 13:28 Vīksna Šogad pirmās sarkanblaktis dārzā, lai gan parasti dārzā agri un daudz, jau domāju, ka nepārziemoja. adata Šīs prot skaistas pārlaist ziemas sezonu un sagaidīt pavasari! adata Vairākas galviņas uz pagaras kājiņas, sporu mākonis dzeltens (ne sarkans, kā šunu daudzpilītei). adata Parasti mazie ērgļi pavasarī uzdzied :) adata Visticamāk kāda inermīzija vai bisonektrija. Ziemelmeita Paldies,Ansi, par ieguldīto laiku sūnu noteikšanā. Lemmus Vīksna Vīksna Lemmus Lemmus |